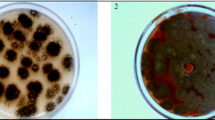

Abstract
l-DOPA (3,4-dihydroxyphenyl-l-alanine), an amino acid derivative is the most widely used drug of choice for the treatment of Parkinson’s disease and other neurologic injuries. The present study deals with the elevated biochemical transformation of l-tyrosine to l-DOPA by Aspergillus niger PA2, a potent tyrosinase producer, isolated from decomposed food wastes. This appears to be the first report on A. niger as a notable extracellular tyrosinase producer. The extracellular tyrosinase activity produced remarkably higher levels of l-DOPA, i.e. 2.44 mg mL−1 when the media was supplemented with 5 mg mL−1 l-tyrosine. The optimum pH for tyrosinase production was 6.0, with the maximal l-DOPA production at the same pH. The product thus produced was analyzed by thin-layer chromatography, UV spectroscopy, high-performance liquid chromatography and Fourier transform infrared spectroscopy, that had denoted this to be l-DOPA. Kinetic parameters viz. Y p/s, Q s and Q p had further indicated the notable levels of production. Thus, Aspergillus niger PA2 could be a promising resource and may be further exploited for large-scale production of l-DOPA.
Similar content being viewed by others
Explore related subjects
Discover the latest articles, news and stories from top researchers in related subjects.Avoid common mistakes on your manuscript.
Introduction
l-DOPA is an amino acid analog and precursor of dopamine which is used as a potent drug for the treatment of Parkinson’s disease, a degenerative disorder which is associated with diminished levels of dopamine in the brain that causes rigidity, tremors, slowness of speech and eventually dementia (Surwase et al. 2012). Administration of dopamine is ineffective for treatment as it cannot cross the blood–brain barrier. l-DOPA is synthesized chemically for pharmaceutical use (Lewitt 2009), which involves multiple steps that are time consuming, eco-unfriendly and uneconomical. In contrast to chemical production, biotechnological production of l-DOPA is an eco-friendly process and turns out in enhanced recovery of product in relatively simpler process conditions. l-DOPA is biotechnologically synthesized from l-tyrosine by a one-step oxidation catalyzed by tyrosinase (Algieri et al. 2012).
Tyrosinase (EC 1.14.18.1) is a type 3 copper protein which is nearly ubiquitously distributed throughout the phylogenetic scale (Gelder et al. 1997; Lerch 1981) which catalyzes the o-hydroxylation of monophenols to the corresponding o-diphenols through monophenolase (cresolase) activity and the oxidation of o-diphenols to the corresponding o-quinones through diphenolase (catecholase) activity using molecular oxygen (Burton 2003; Claus and Decker 2006; Wan et al. 2009). Further, o-quinones polymerize into brown-black pigment through a series of enzymatic and non-enzymatic reactions. Consequently, tyrosinase has got additional widespread industrial applications for instance in the environmental technology for the bioremediation of phenol-containing waste water and contaminated soils (Claus and Filip 1988), as biosensors for the monitoring of phenols, in pharmaceutical industries for the biosynthesis of o-diphenols (Agarwal et al. 2014), in cosmetic and food industries due to either undesirable or beneficial oxidative browning reactions (Mayer and Harel 1978).
The native tyrosinases are generally intracellular (Halaouli et al. 2006), although recently Gasparetti et al. (2012) and Zou et al. (2014) had reported extracellular tyrosinase production from fungi Trichoderma reesei and Auricularia auricular, respectively. In addition, the l-DOPA production has been observed from some fungal species such as Aspergillus oryzae (Ali et al. 2007; Haneda et al. 1971), Acremonium rutilum (Krishnaveni et al. 2009) and also from Aspergillus niger (Ali and Haq 2010), but the l-DOPA is being produced in lower quantity and is rapidly converted to another intermediate dopaquinone or the final product melanin during metabolism (Ali et al. 2007; Rani et al. 2007).
The work undertaken describes the isolation and identification of a fungal strain and illustrates the first report of significant levels of extracellular tyrosinase production by the isolate Aspergillus niger PA2 and also its exploitation for the biotransformation of l-tyrosine to l-DOPA. Further, chromatographic and spectroscopic analyses of the product had denoted it to be l-DOPA.
Materials and methods
Chemicals
l-Tyrosine and l-DOPA were purchased from Himedia (India), copper sulfate, l-ascorbic acid and all other fine chemicals were purchased from Merck (India).
Isolation and molecular identification of PA2
Strain PA2 was isolated from effluent from food industry. Molecular identification of isolate was carried out following amplification and sequence analysis of partial 18S, complete internal transcribed spacers, complete 5.8S and partial 28S (18S-ITS1-5.8S-ITS2-28S) regions of rDNA gene. Genomic DNA from the strain was isolated using the Insta GeneTM Genomic DNA isolation kit (Bio-Rad). PCR amplification of the ITS region was carried out using universal fungal specific primers (Table 1) (White et al. 1990). Amplification was carried out in PTC-225 Thermal Cycler (MJ Research, USA) with one cycle of 94 °C for 2 min followed by 35 cycles of denaturation (45 s at 94 °C), annealing (60 s at 55 °C), extension (60 s at 72 °C) and a final extension step at 72 °C for 10 min. Amplified product obtained was purified using PCR clean up kit (Millipore) and sequenced. The ITS region sequence obtained was analyzed and aligned with its similar sequences through Blast-n at NCBI server (http://www.ncbi.nlm.nih.gov/BLAST). The phylogeny analysis of the sequence with the closely related sequences of blast result was performed using Phylogeny.fr program (http://www.phylogeny.fr/index.cgi).
Culture media
Fungal strain PA2 was grown and stored onto potato dextrose agar medium (2 % dextrose, 2 % agar, 20 % potato). For the production of tyrosinase, Vogel’s medium (Vogel 1956) was employed containing (as g L−1) Na-citrate, 15; KH2PO4, 25; MgSO4·7H2O, 1; CaCl2·H2O, 0.5; supplemented with 2 % glucose and trace element solution: 0.1 % containing (as g L−1) ZnSO4·7H2O, 2.5; Fe(NH4)2(SO4)2·6H2O, 0.5; CuSO4·5H2O, 0.125; MnSO4·H2O, 0.025; H3BO3, 0.025; H3P(Mo3O10)·H2O, 0.025.
Estimation of tyrosinase activity
The tyrosinase activity was determined by the previously described method using l-tyrosine as substrate (Arica et al. 2004; Chen et al. 2001; Liu et al. 2004; Raval et al. 2012). For this 100 mL of Vogel’s medium was inoculated with 1 mL of mycelium suspension. Cultures were grown in conical flasks (250 mL) with shaking (150 rpm) at 30 °C for 240 h. 0.1 mL of supernatant of cell free extract was collected from these flasks and assayed. Standard reaction mixture consisted of 1 mL of 0.5 M phosphate buffer, pH 6.5; 1 mL of 0.001 M l-tyrosine with 2 % l-ascorbic acid and 0.1 mL of culture supernatant in a total volume of 3 mL. The reaction mixture without culture supernatant was used as enzyme blank. Tyrosinase activity was estimated at 280 nm for 10 min using CARY 100 Bio UV–Vis spectrophotometer (Agilent technologies, USA). One unit of tyrosinase activity was equal to a ΔA280 of 0.001/min at 30 °C in a 3.0 mL reaction mixture containing l-tyrosine and l-ascorbic acid. All experiments were carried out in triplicate. The Y error bars in the figures indicate the standard error of the mean. The enzyme activity was calculated by following formula:
df dilution factor.
l-DOPA production
A. niger PA2 was grown in the Vogel’s medium supplemented with 3 mg mL−1 l-tyrosine and 2 % l-ascorbic acid to produce l-DOPA. l-DOPA production in shake-flask cultures was estimated at 30 °C under reducing conditions. The kinetic parameters for l-DOPA production and l-tyrosine consumption were enumerated as described before (Pirt 1975; Surwase and Jadhav 2011). Kinetic parameters analyzed were product yield coefficient (Y p/s, mg of l-DOPA produced/mg of substrate consumed), volumetric rate for substrate utilization (Q s, mg of substrate consumed/mL of media/h) and volumetric rate of product formation (Q p, mg of l-DOPA produced/mL of media/h).
Assay for l-DOPA
Cell free culture extract was withdrawn from these flasks periodically, centrifuged at 4000 rpm for 15 min and the amount of l-DOPA was determined according to the Arnow’s method (Arnow 1937). Briefly, culture supernatant (1 mL) was added with 1 mL of 0.5 M HCl and 1 mL of nitrate/molybdate reagent (giving yellow color), 1 mL of 1 M NaOH (giving red color). Water was added to make a final volume of 5 mL. l-DOPA was estimated spectrophotometrically at 590 nm.
Determination of optimal conditions for tyrosinase activity and l-DOPA production
A. niger PA2 was grown in the Vogel’s medium supplemented with 3 mg mL−1 l-tyrosine and 2 % l-ascorbic acid under shaking conditions for further analysis. The effect of pH of the culture medium on tyrosinase activity and l-DOPA production was studied at varying pH (4.0–8.0) while maintaining the other process variables, i.e., with 3 mg mL−1 l-tyrosine at 30 °C. For these two different buffer systems acetate buffer (for pH 4.0–5.0) and phosphate buffer (for pH 6.0–8.0) were employed. To find out the optimal temperature for tyrosinase activity and l-DOPA production a temperature range of 20–45 °C was employed with 3 mg mL−1 l-tyrosine at constant pH, i.e., 6.0. Further, to determine the optimal substrate concentration for enzyme activity and l-DOPA production, culture medium was supplemented with varying concentrations of l-tyrosine (1–6 mg mL−1), the preferred substrate for the tyrosinase at constant pH and temperature, i.e., 6.0 and 30 °C, respectively. All experiments were performed in triplicates for up to 240 h.
Analytical procedures
A. niger PA2 was grown in the Vogel’s medium supplemented with 5 mg mL−1 l-tyrosine and 2 % l-ascorbic acid to produce l-DOPA at pH 6.0 and at 30 °C under shaking conditions. After 144 h of incubation, supernatant of the cell free culture extract from these flasks was collected and subjected to further analysis.
TLC
The above culture supernatant comprising of l-DOPA was centrifuged at 15,000 rpm for 10 min and the clear supernatant was filtered through 0.45 µm membrane filter. 2 μL of standard l-tyrosine (0.5 mg mL−1), standard l-DOPA (0.5 mg mL−1) and cell free culture supernatant were loaded on precoated silica gel F254 (20 × 20 cm) aluminum sheet (Merck) using n-butanol:acetic acid:water (4:1:2, v/v) as solvent system. The chromatograms were developed by spraying with ninhydrin reagent and were heated at 110 °C for 10 min. Spots were visualized under UV and R f values of resolved bands were calculated (Gunendi and Pamuk 1999; Krishnaveni et al. 2009; Sukumaram et al. 1979).
UV-spectral analysis
The l-DOPA pellet obtained from the above reaction mixture was dissolved in small volume of 0.1 N HCl and the resulting solution was used for UV–Vis spectral analysis. Study was carried out using CARY 100 Bio UV–Vis spectrophotometer (Agilent technologies, USA) and changes in its absorption spectrum (200–500 nm) were recorded.
HPLC
HPLC analysis was carried out using a Shimadzu system with a C18 column (4.6 × 250 mm, 5 µm) and a water:methanol (80:20) mobile phase with a flow rate of 0.5 mL min−1 for 20 min and a UV detector set at 280 nm (Rani et al. 2007; Surwase et al. 2012). The standard l-tyrosine (5 µg mL−1), l-DOPA (5 µg mL−1) and samples were prepared in the mobile phase, filtered and then degassed by sonication for 30 min and were injected into the HPLC column (Surwase and Jadhav 2011).
FTIR analysis
FTIR analysis of the l-DOPA was carried out with Thermo Nicolet, Nexus spectrometer at room temperature and changes in percentage transmission at different wavelengths (500–4000 cm−1) were recorded. An infrared spectrum of the fingerprint region of a thin film, deposited from the l-DOPA was compared to a reference spectrum of l-DOPA standard.
Results
Molecular identification of fungal isolate PA2
Identification based on partial 18S, complete internal transcribed spacers, complete 5.8S and partial 28S (18S-ITS1-5.8S-ITS2-28S) domains (∼1155 bp, Fig. 1) of rDNA gene had indicated PA2 to be the strain of A. niger as it showed highest homology to it. The phylogenetic tree was generated using the top hits obtained against ITS gene sequence of PA2 after performing BLAST-n and there was no missing data for a specific rDNA region in the accessions obtained from GenBank. For the BLAST-n analysis, gaps in the alignment were positioned to minimize nucleotide mismatches. PA2 exhibited maximum identity, i.e., 92 % with A. niger MBL1511 as evident from Fig. 2. The size range of ITS regions of Aspergillus niger PA2 was about 1155 bp and the sequence of the same was deposited in the GenBank under the accession number KJ701548.1.
Estimation of tyrosinase activity
When inoculated in Vogel’s medium, A. niger PA2 led into a red-brownish appearance to the media after 48–72 h of incubation, that gradually changed to black (melanin formation), indicative of the fact that the isolate was tyrosinase producer. The tyrosinase activity gradually increased for up to 168 h with a maximum of 180 IU mL−1 (Fig. 3a) in the extracellular medium. The activity decreased thereafter to 20 IU mL−1. Furthermore, broth color also changed from colorless (0 h) to red (144 h) and to black at the end of the incubation (240 h), suggesting the formation of melanin-like pigments, as observed by Mason (2003).
l-DOPA production
Addition of nitrite–molybdate reagent to fresh extracts of developing sporangia led to the formation of yellow color. Further, addition of sodium hydroxide resulted in the development of a red color, similar to the one developed with standard DOPA solution. l-DOPA levels obtained were 2.19 mg mL−1 (Fig. 3b) after 120 h of incubation in shake flasks at 30 °C. Culture media were added with ascorbate for inhibiting the conversion of l-DOPA to dopaquinone, as reported earlier (Haq et al. 2003). The l-DOPA production declined after 144 h presumably due to the conversion of l-DOPA to other metabolites (Lerch 1981; Para and Baratti 1984).
pH dependence of tyrosinase activity and l-DOPA production
Fungal growth varied according to the pH of the culture medium and so as the tyrosinase activity. pH has considerably affected the enzyme activity, as demonstrated in Fig. 4a. At acidic conditions (pH 4.0), the tyrosinase activity was as low as 168 IU mL−1. An optimal pH of 6.0 had resulted in the maximum tyrosinase activity (296 IU mL−1). Further increase in pH led to a decrease in enzyme activity, i.e., 164 IU mL−1 at pH of 7.0, which declined to 49 IU mL−1 at pH 8.0.
There was a gradual increase in l-DOPA production when pH of the culture medium increased from 4.0 to 6.0 (Fig. 4a). Maximum production (2.43 mg mL−1) was obtained at pH 6.0. Further increase in pH (7.0–8.0) resulted in decreased formation of l-DOPA. These observations demonstrated that pH of the reaction mixture significantly affects the production of l-DOPA. The hydroxylation reaction of l-DOPA from l-tyrosine proceeds preferentially at this pH range and degradative reaction of the l-DOPA formed scarcely occurs, consequently the product gets stabilized. At the neutral or alkaline pH range, l-DOPA gets decomposed to further metabolites, such as dopaquinone and melanin (Ali and Haq 2006; Surwase et al. 2012) and l-DOPA does not accumulate.
Optimal temperature for tyrosinase activity and l-DOPA production
At extreme high or low incubation temperatures, tyrosinase production by the cells decreased (Fig. 4b). Maximum tyrosinase activity (169 IU mL−1) was observed at 30 °C. An increase or a decrease in temperature had significantly lowered the enzyme activity.
l-DOPA production was highest at an incubation temperature of 30 °C, i.e., 2.4 mg mL−1. Lowering (20 °C) or increasing (45 °C) the temperature significantly reduced the production levels to 1 and 0.9 mg mL−1, respectively.
Optimal substrate concentration
Increasing the concentration of l-tyrosine from 1 to 5 mg mL−1 resulted in increased levels of tyrosinase production and l-tyrosine at 5 mg mL−1 levels led to maximal levels of tyrosinase (250 IU mL−1) (Fig. 4c).
As l-tyrosine concentration was increased up to 5 mg mL−1, l-DOPA production increased gradually, but further increase in the l-tyrosine concentration resulted in a decreased l-DOPA production. This might be due to the lower solubility of the higher l-tyrosine concentration in neutral and alkaline conditions. The optimum l-tyrosine concentration was found to be 5 mg mL−1, at which notably higher l-DOPA yield (2.44 mg mL−1) was achieved after 120 h of incubation.
Kinetic parameters for the biotransformation of l-tyrosine to l-DOPA with initial and optimized substrate concentrations were enumerated and showed significance at P < 0.0005 (Table 2). There was a 20 % increase in product yield coefficient after optimizing the l-tyrosine concentration in the media (Y p/s) and also a significant enhancement in volumetric rate of product formation (Q s), while a lowering in volumetric rate for substrate utilization was observed (Q p).
Analytical evaluation for l-DOPA production
TLC
Dark single bands appeared on Silica gel G plates after ninhydrin spray for standard l-DOPA and standard l-tyrosine with an R f value of 0.52 and 0.64, respectively (Fig. 5a). Reaction mixture supernatant showed two distinct reddish brown spots, which had an R f value of 0.51 and 0.65, corresponding to the standard l-DOPA and l-tyrosine, respectively, primarily denoting the production of l-DOPA in the culture supernatant.
a TLC analysis denoting 1 standard l-tyrosine; 2, 3 reaction mixture supernatants under optimized conditions (5 mg mL−1 l-tyrosine with pH 6.0 at 30 °C) and 4 standard l-DOPA and b UV-spectral analysis of 1 standard l-DOPA and 2 reaction mixture supernatant under optimized conditions after 144 h of incubation
UV-spectral analysis
The UV spectrum of l-DOPA, obtained from A. niger PA2 culture supernatant was markedly similar to the spectrum of standard l-DOPA solution, with an absorption peak at 280 nm, as depicted in Fig. 5b
HPLC
The HPLC elution profile of the reaction mixture showed peaks at a similar retention time to that of standard l-DOPA at 280 nm, thus substantiating the l-DOPA production (Fig. 6). Standard l-tyrosine and standard l-DOPA were eluted at retention time 9.239 and 8.105 min, respectively, and the reaction mixture showed the elution peak at a retention time of 8.082 min.
FTIR analysis
Characteristic patterns between the FTIR spectra of synthesized and standard l-DOPA spectra were evident (Fig. 7). The carboxylic group for l-DOPA illustrated absorption peak at 1240 cm−1 (C–O stretching) and small peaks at 1400–1440 cm−1 (O–H bending vibration). The bands at 3350–3355 and 3180–3190 cm−1 are characteristic to the ν(N–H) and ν(O–H) vibrations, respectively. The peaks between 1060 and 1065 cm−1 and at around 1200 cm−1 were present due to C–N stretching. The band at 1495 cm−1 is distinct for C=C bond in the benzene ring (Kura et al. 2013).
Discussion
Tyrosinases have been exploited for a variety of biotechnological applications (Halaouli et al. 2006) and therefore have attracted various groups involved in molecular characterization and bioengineering studies. In the present work a fungal strain PA2, capable of producing l-DOPA was isolated and identified as Aspergillus niger following the rDNA gene sequencing and phylogenetic analysis. Although l-DOPA was produced by other fungal species such as Aspergillus oryzae (Ali et al. 2007; Haneda et al. 1971), Acremonium rutilum (Krishnaveni et al. 2009) and also from Aspergillus niger (Ali and Haq 2010), but as observed, tyrosinases are generally intracellular and are produced in lower quantity. Only few reports are there stating extracellular tyrosinase production such as Gasparetti et al. (2012) and Zou et al. (2014) had recently reported extracellular tyrosinase production from fungi Trichoderma reesei and Auricularia auricular, respectively. This appears to be the first report on A. niger as a remarkable extracellular tyrosinase producer. Maximum tyrosinase activity up to 180 IU mL−1 was obtained following 168 h of incubation. So far there is no report denoting the comparable levels of extracellular tyrosinase from any fungal isolate.
High tyrosinase activity (165 IU mL−1) observed following 144 h of incubation has resulted in notably higher levels of l-DOPA (2.18 mg mL−1). pH drastically affected both tyrosinase activity and l-DOPA production. The optimum pH examined was 6.0, at which 2.43 mg mL −1 of l-DOPA was produced with 2.9 mg mL−1 l-tyrosine consumption. A pH of 3.5 and 5.5 had previously been reported for the biosynthesis of l-DOPA from A. oryzae and Y. lipolytica, respectively (Ali et al. 2007; Ali and Haq 2006). Higher level of acidic and alkaline pH resulted in lower l-DOPA yield, possibly because of decreased cellular metabolism and cell viability, affecting in turn the tyrosinase activity. In addition, at basic pH, the l-DOPA yield was lower due to the instantaneous conversion of l-DOPA into further metabolites such as dopaquinone and melanin (Ali and Haq 2006; Surwase et al. 2012). Incubation temperature of the culture medium had a significant effect on tyrosinase activity and l-DOPA production. Maximum tyrosinase activity (172 IU mL−1) was observed at 30 °C along with higher l-DOPA production (2.4 mg mL−1). A further increase or decrease in temperature had resulted in diminished tyrosinase activity possibly because of deregulated fungal physiology and metabolism, which in turn had resulted in lesser l-DOPA production. l-Tyrosine concentration had also affected the tyrosinase activity as well as l-DOPA yield. Lee et al. (1996) had also obtained the higher yield of l-DOPA at the substrate concentration ranging between 2.0 and 5.0 mg mL−1. Similar results were obtained by Krishnaveni et al. (2009). Further, a substrate concentration of 2 mg mL−1 had resulted in 1.4 mg mL−1 of l-DOPA from the mutant strain of actinomycetes (Sukumaram et al. 1979). Product levels were as low as 0.488 mg mL−1 from plant sources (Rani et al. 2007).
Production of l-DOPA was corroborated by chromatographic and spectral analysis of the reaction mixture. The TLC profile showed two fine peaks at 0.51 and 0.65 with a similar R f value to the standard l-DOPA and l-tyrosine. UV and FTIR spectral analysis of the product was also similar to that of the standard l-DOPA, substantiating the production of l-DOPA in the broth. In addition, the HPLC profile of the product illustrated a distinct peak at a retention time of 8.082 min, same as the standard l-DOPA (8.105 min), demonstrating therefore the production of l-DOPA.
Use of whole cells as catalysts in the present study had also been explored by other investigators (Ali et al. 2007; Krishnaveni et al. 2009). The use of intact cells has pronounced advantages as these could be subjected for multiple cycles of production and also they offer favorable environment with necessary co-factors for the regeneration of active sites (Pollard and Woodley 2007; Rao et al. 2011). Further, purification, specific activity and kinetic parameter analysis and study of catalytic mechanism of A. niger PA2 tyrosinase may enable in developing an improved system for achieving elevated yields of l-DOPA.
Conclusions
Fungal strain A. niger PA2 exploited in the present study had demonstrated for the first time notably significant levels of extracellular tyrosinase levels which was further evaluated for the production of l-DOPA, a compound of clinical and biomedical significance. The optimization of pH, temperature and substrate concentration had resulted in the enhanced production of l-DOPA. l-DOPA was thus produced extracellularly by an intact cell system and therefore avoiding an elaborate and complex cell disruption step that could be tedious and uneconomical. Further, elucidation of an insight into catalytic mechanism of A. niger PA2 tyrosinase may enable in developing a simpler and industrially feasible fungal system for achieving higher yields and cost effective production of l-DOPA.
References
Agarwal P, Saroj S, Dubey S, Singh RP (2014) l-Tyrosinase— a multifunctional enzyme: structural and molecular features. In: Thakur JK (ed) Gene and Protein Engineering, 5th edn. Studium Press, LLC, Houston, pp 427–444
Algieri C, Donato L, Bonacci P, Giorno L (2012) Tyrosinase immobilized on polyamide tubular membrane for the l-DOPA production: total recycle and continuous reactor study. Biochem Eng J 66:14–19
Ali S, Haq I (2006) Kinetic basis of celite (CM 2:1) addition on the biosynthesis of 3,4-dihydroxyphenyl-l-alanine (l-DOPA) by Aspergillus oryzae ME2 using l-tyrosine as a basal substrate. World J Microbiol Biotechnol 22:347–353
Ali S, Haq I (2010) Production of 3,4 dihydroxy l-phenylalanine by a newly isolated Aspergillus niger and parameter significance analysis by Plackett Burman design. BMC Biotechnol 10:86
Ali S, Shultz JL, Haq I (2007) High performance microbiological transformation of l-tyrosine to l-dopa by Yarrowia lipolytica NRRL-143. BMC Biotechnol 7:50
Arica MY, Bayramoglu G, Bicak N (2004) Characterization of tyrosinase immobilized onto spacer-arm attached glycidyl methacrylate-based reactive microbeads. Process Biochem 39:2007–2017
Arnow EL (1937) Colorimetric determination of the components of l-3, 4-dihydroxy phenyl alanine–tyrosine mixtures. J Biol Chem 118:531–537
Burton SG (2003) Oxidizing enzymes as biocatalysts. Trends Biotechnol 21:543–549
Chen T, Vazquez-Duhalt R, Wu CF, Bentley WE, Payne GF (2001) Combinatorial screening for enzyme-mediated coupling. tyrosinase-catalyzed coupling to create protein–chitosan conjugates. Biomacromolecules 2:456–462
Claus H, Decker H (2006) Bacterial tyrosinases. Syst Appl Microbiol 29:3–14
Claus H, Filip Z (1988) Behaviour of phenoloxidases in the presence of clays and other soil-related adsorbents. Appl Microbiol Biotechnol 28:506–511
Gasparetti C, Nordlund E, Jänis J, Buchert J, Kruus K (2012) Extracellular tyrosinase from the fungus Trichoderma reesei shows product inhibition and different inhibition mechanism from the intracellular tyrosinase from Agaricus bisporus. Biochim Biophys Acta 1824:598–607
Gelder CWG, Flurkey WH, Wichers HJ (1997) Sequence and structural features of plant and fungal tyrosinases. Phytochemistry 45:1309–1323
Gunendi G, Pamuk F (1999) Thin layer chromatographic separation and quantitation of l-dopa and l-tyrosine in mixtures. Turk J Chem 23:269–273
Halaouli S, Asther M, Sigoillot JC, Hamdi M, Lomascolo A (2006) Fungal tyrosinases: new prospects in molecular characteristics, bioengineering and biotechnological applications. J Appl Microbiol 100:219–232
Haneda K, Watanabe S, Takeda I (1971) Synthesis of l-3,4-dihydroxyphenylalanine from l-tyrosine by microorganisms. Appl Microbiol 22:721–722
Haq I, Ali S, Qadeer MA, Iqbal J (2003) Inducive effect of cresoquinone on microbiological transformation of l-tyrosine to 3,4 dihydroxy phenyl l-alanine by Aspergillus oryzae NG-11P1. Appl Microbiol Biotechnol 60:696–699
Krishnaveni R, Rathod V, Thakur MS, Neelgund YF (2009) Transformation of l-Tyrosine to l-DOPA by a novel fungus, Acremonium rutilum under submerged fermentation. Curr Microbiol 58:122–128
Kura AU, Hussein SH, Hussein MZ, Fakurazi S, Arulselvan P (2013) Development of a controlled-release anti-parkinsonian nanodelivery system using levodopa as the active agent. Int J Nanomed 8:1103–1110
Lee SG, Rao HS, Hong SP, Kim EH, Sung MH (1996) Production of l-dopa by thermostable tyrosine phenol-lyase of a thermophilic Symbiobacterium spp. over expressed in recombinant Escherichia coli. J Microb Biotechnol 6:98–102
Lerch K (1981) Copper monooxygenases: tyrosinase and dopamine 1-monooxygenase. In: Siegel H (ed) Metal ions in biological systems. Marcel Dekker, New York, pp 143–186
Lewitt PA (2009) Levodopa therapeutics for Parkinson’s disease: new developments. Parkinsonism Relat Disord 15:S31–S34
Liu N, Zhang T, Wang YJ, Huang YP, Ou JH, Shen P (2004) A heat inducible tyrosinase with distinct properties from Bacillus thuringiensis. Lett Appl Microbiol 39:407–412
Mason HS (2003) Mechanism of the oxidation of dihydroxyphenylalanine by tyrosinase. J Biol Chem 172:83–99
Mayer AM, Harel E (1978) Polyphenol oxidases in plants. Phytochemistry 18:193–215
Para GM, Baratti JC (1984) Effect of culture conditions on the production of tyrosine phenol-lyase by Erwinia herbicola. Appl Environ Microbiol 48:1256–1258
Pirt SJ (1975) Principles of cell and microbe cultivation. Blackwell, London
Pollard DJ, Woodley JM (2007) Biocatalysis for pharmaceutical intermediates: the future is now. Trends Biotechnol 25:66–73
Rani N, Joy B, Abraham TE (2007) Cell suspension cultures of Portulaca grandiflora as potent catalysts for biotransformation of l-tyrosine into l-DOPA, an anti-Parkinson’s drug. Pharm Biol 45:48–53
Rao A, Pimprikar P, Bendigiri C, Kumar AR, Zinjarde S (2011) Cloning and expression of a tyrosinase from Aspergillus oryzae in Yarrowia lipolytica: application in l-DOPA biotransformation. Appl Microbiol Biotechnol 92:951–959
Raval KM, Vaswani PS, Majumder DR (2012) Biotransformation of a single amino-acid l-Tyrosine into a bioactive molecule l-DOPA. Int J Sci Res Publ 2(5):2250–3153
Sukumaram CP, Singh DV, Khedkar PD, Mahadevan PR (1979) An actinomycete producing l-3,4-dihydroxyphenylalanine from l-tyrosine. J Biosci 1:236–239
Surwase SN, Jadhav JP (2011) Bioconversion of l-tyrosine to l-DOPA by a novel bacterium Bacillus sp. JPJ. Amino Acids 41:495–506
Surwase SN, Patil SA, Apine OA, Jadhav JP (2012) Efficient microbial conversion of l-tyrosine to l-DOPA by Brevundimonas sp. SGJ. Appl Biochem Biotechnol 167:1015–1028
Vogel HJ (1956) A convenient growth medium for Neurospora (medium N). Microb Genet Bull 13:42–43
Wan X, Chai B, Liao Y, Su Y, Ye T, Shen P, Chen X (2009) Molecular and biochemical characterization of a distinct tyrosinase involved in melanin production from Aeromonas media. Appl Microbiol Biotechnol 82:261–269
White TJ, Bruns T, Lee S, Taylor J (1990) Amplification and direct sequencing of fungal ribosomal RNA genes for phylogenetics. PCR protocols: a guide to methods and applications. Academic, New York, pp 315–322
Zou Y, Hu W, Jiang A, Ma K (2014) Partial purification and characterization of a novel extracellular tyrosinase from Auricularia auricula. Appl Biochem Biotechnol 172:1460–1469
Acknowledgments
Research fellowships awarded to PA by University Grant Commission, Govt. of India, to NP by Council of Scientific and Industrial Research, Govt. of India, to SS by Department of Biotechnology Govt. of India and to JS by Ministry of Human Resource Development, Govt. of India are gratefully acknowledged.
Author information
Authors and Affiliations
Corresponding author
Ethics declarations
Conflict of interest
The authors declare that they have no conflict of interest.
Ethical approval
This article does not contain any studies with human participants or animals performed by any of the authors.
Additional information
Handling Editor: J. G. López.
Rights and permissions
About this article
Cite this article
Agarwal, P., Pareek, N., Dubey, S. et al. Aspergillus niger PA2: a novel strain for extracellular biotransformation of l-tyrosine into l-DOPA. Amino Acids 48, 1253–1262 (2016). https://doi.org/10.1007/s00726-016-2174-7
Received:
Accepted:
Published:
Issue Date:
DOI: https://doi.org/10.1007/s00726-016-2174-7